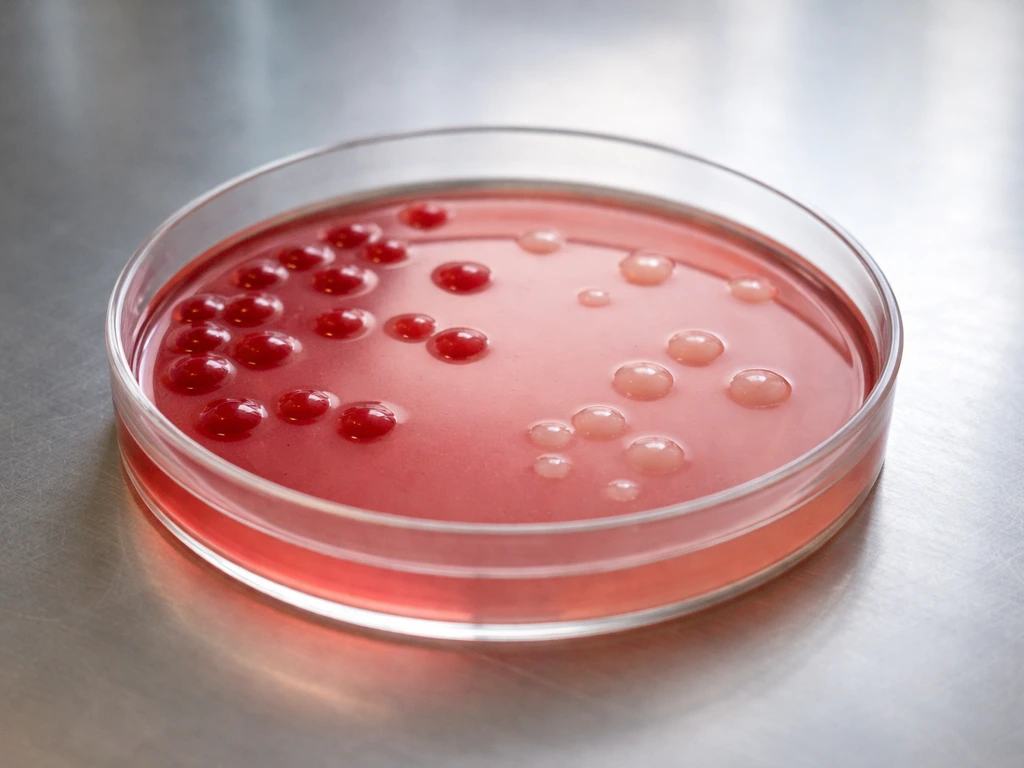
Close-up of MacConkey agar petri dish showing distinct colony colors on a minimal lab bench
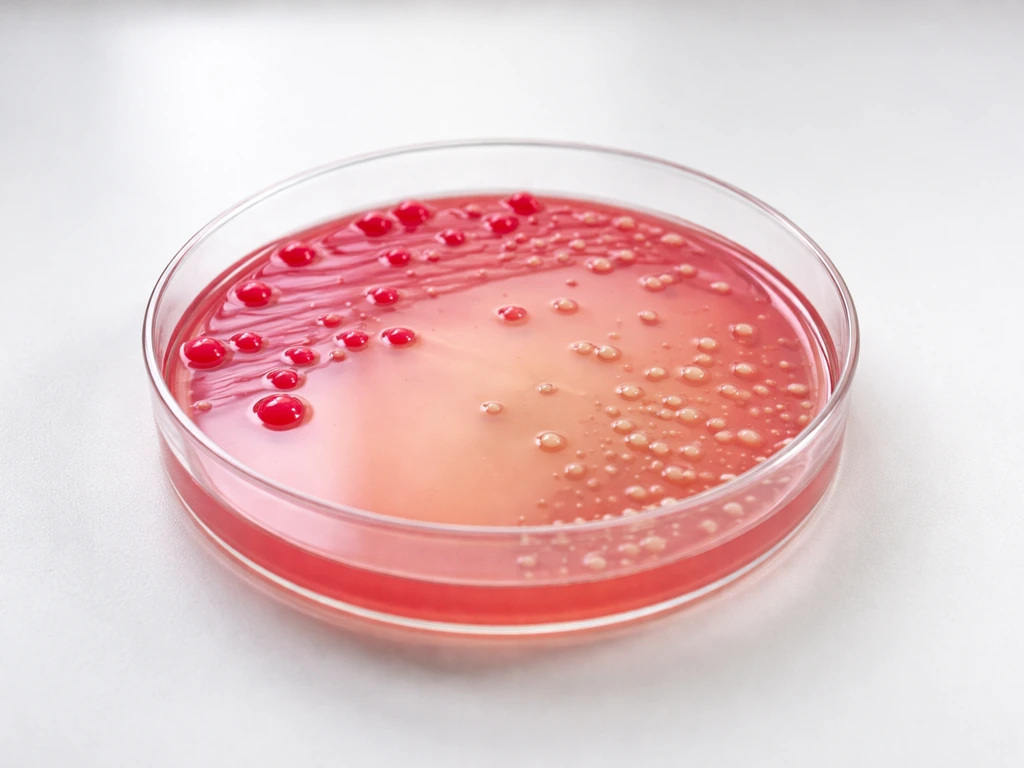
Close-up of MacConkey agar Petri dish with pink lactose-fermenting colonies and pale non-fermenting colonies.
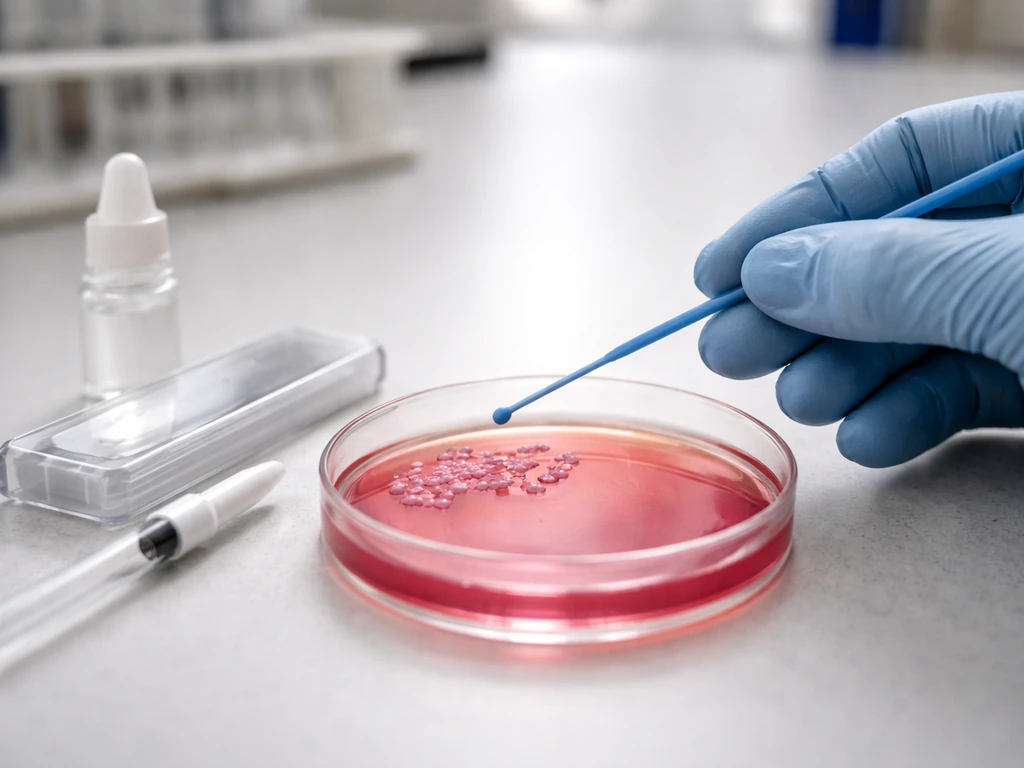
Technician’s gloved hand transferring a colony from a MacConkey agar plate for confirmatory Gram staining

Gram-positive bacteria generally cannot grow on MacConkey agar. The medium is specifically designed to block them using two selective agents: crystal violet and bile salts. Most Gram-positives are inhibited completely, which is exactly the point. MacConkey is built to recover Gram-negative enteric bacteria, particularly from food, water, and clinical samples, while suppressing the rest of the plate's potential residents.
Can Gram-Positive Bacteria Grow on MacConkey Agar?
What MacConkey agar selects for
MacConkey agar is both selective and differential. Selective means it is engineered to encourage some bacteria and discourage others. Differential means it can tell those surviving bacteria apart based on a visible reaction. The FDA Bacteriological Analytical Manual lists the key components of standard MacConkey agar as lactose (10 g/L), bile salts (9.0 g/L), neutral red indicator (0.03 g/L), crystal violet dye (0.001 g/L), and peptone as a nutrient base.
The target organisms are Gram-negative enteric bacteria, especially members of the Enterobacteriaceae family and related groups. The differential readout relies on lactose fermentation: bacteria that break down lactose produce acid, which drops the local pH and causes the neutral red indicator to shift color. Strong lactose fermenters produce bright pink to red colonies. Non-lactose fermenters appear colorless to off-white, with relatively clear surrounding agar.
Can Gram-positive bacteria grow on MacConkey agar
The direct answer is: almost never under standard conditions, and that is intentional. MacConkey agar is specifically formulated so that Gram-positive bacteria cannot establish growth. Staphylococcus aureus, for example, shows 0% recovery on standard MacConkey formulations. Most other Gram-positives behave the same way.
There are narrow exceptions. Enterococcus faecalis can produce fair to good growth (roughly 30 to 40% recovery in some formulations), with colonies appearing colorless to pale pink. Some vendor technical sheets also note that staphylococci can occasionally produce pale pink to red colonies on certain MacConkey formulations, though this is not the norm. These exceptions matter for troubleshooting, but they do not change the general rule: if you see a robust colony on MacConkey, your first assumption should be a Gram-negative organism.
Typical non-growth and exceptions
The organisms you will almost never recover on standard MacConkey agar include the following categories of Gram-positives:
- Staphylococcus aureus and most other staphylococci (fully inhibited on standard formulations)
- Streptococcus species (inhibited by crystal violet and bile salts)
- Bacillus species (inhibited under standard conditions)
- Listeria monocytogenes (no significant growth on standard MacConkey)
- Clostridium species (inhibited, and most are also anaerobic)
The partial exceptions are Enterococcus species. Enterococci have intrinsic resistance to bile, which is why they can sometimes survive the selective pressure of MacConkey agar at a reduced rate. Their growth is typically poor compared to the robust colonies you get from enteric Gram-negatives, and the colonies appear colorless or faintly pink rather than bright. Some MacConkey formulations with slightly different bile salt concentrations or crystal violet levels will show more or less enterococcal breakthrough, which is why reading the specific product's technical data sheet matters.
What bacteria do grow on MacConkey agar
The organisms that thrive on MacConkey are the Gram-negative enteric bacteria. Here is how the most common ones appear:
| Organism | Gram stain | Lactose fermentation | Colony appearance on MacConkey |
|---|---|---|---|
| Escherichia coli | Negative | Yes (strong) | Bright pink to red, often with a metallic sheen or surrounding precipitate |
| Klebsiella pneumoniae | Negative | Yes (strong) | Large, mucoid, bright pink colonies |
| Salmonella spp. | Negative | No | Colorless to off-white, translucent |
| Shigella spp. | Negative | No | Colorless, flat, translucent |
| Proteus vulgaris | Negative | No (typically) | Colorless, may show slight spreading or swarming |
| Pseudomonas aeruginosa | Negative | No | Colorless to pale, sometimes with a slight pigment or flat spreading morphology |
| Enterobacter spp. | Negative | Yes | Pink, mucoid colonies |
| Burkholderia cepacia complex | Negative | Variable | Rare on MacConkey; occasional purple-pigmented colonies reported |
Salmonella is a good example of a clinically and food-safety-relevant non-lactose fermenter: it grows well on MacConkey but stays colorless, which is one reason MacConkey is used as part of Salmonella isolation workflows. Pseudomonas aeruginosa similarly grows on MacConkey as a non-fermenter, though it is not an enteric organism in the traditional sense. Burkholderia cepacia complex is worth mentioning separately because while it can grow on MacConkey in some cases, recovery is inconsistent, and specific selective agars perform much better for that organism.
Why Gram-positives generally can't grow there
The mechanism comes down to two components working together: crystal violet and bile salts.
Crystal violet is a dye that interferes with cell wall synthesis and penetrates Gram-positive cell walls more readily, disrupting membrane integrity. Gram-positive bacteria have a thick peptidoglycan layer but lack the outer membrane that characterizes Gram-negatives. That outer membrane acts as a barrier, keeping crystal violet from getting in easily. Gram-positives do not have that barrier, so they are far more vulnerable to the dye's toxic effects.
Bile salts work by disrupting cell membranes. They are detergent-like compounds that are naturally found in the intestine, which is exactly where enteric bacteria evolved to live. Gram-negative enteric bacteria have adapted to survive bile. Gram-positives, with the exception of bile-tolerant organisms like enterococci, are killed or severely inhibited by bile salt concentrations present in MacConkey agar (9.0 g/L). The combination of both agents creates a selective environment where Gram-negatives have a major survival advantage. The neutral red and lactose then handle the differentiation part, producing that characteristic color-based readout.
This same logic applies to differential media used in other contexts. Mannitol salt agar, for instance, flips the selectivity in the opposite direction, selecting for salt-tolerant organisms like staphylococci while suppressing Gram-negatives. On mannitol salt agar, mannitol and the high salt select for salt-tolerant bacteria such as staphylococci while suppressing Gram-negative organisms selecting for salt-tolerant organisms like staphylococci. Does Proteus vulgaris grow on mannitol salt agar? It is typically suppressed because mannitol salt agar is formulated for salt-tolerant Gram-positive organisms like Staphylococcus. Understanding which agent blocks which organism type is the key to choosing and interpreting selective media correctly.
Practical troubleshooting: interpreting results, contamination checks, and next tests
If you are seeing unexpected growth on MacConkey agar, here is a structured way to think through what might be happening.
Unexpected colonies appeared on the plate
First, check your incubation parameters. Standard incubation for MacConkey is 35 to 37°C (food and environmental labs sometimes use 30 to 35°C) for 18 to 24 hours. Prolonged incubation beyond 48 hours can produce misleading results, including breakthrough growth from weakly inhibited organisms and color changes in the agar that are not meaningful. Some product instructions explicitly warn against incubating longer than 48 hours for exactly this reason. If your plate sat too long, that is your first suspect.
Second, consider the inoculum. Heavy inoculation with a Gram-positive-rich sample can sometimes allow a few cells to survive selective pressure just by sheer numbers. This is not true growth so much as survival of inoculated cells, and the colonies will typically be small, sparse, and poorly developed compared to Gram-negative colonies.
Colonies are colorless and you expected a fermenter
Colorless colonies on MacConkey mean the organism either does not ferment lactose or is doing so too slowly to register within your incubation window. Salmonella, Shigella, Pseudomonas, and Proteus all fall into this category. Does Proteus vulgaris grow on MacConkey agar? It does not typically establish growth there under standard selective conditions. Do not assume colorless equals negative. A colorless colony is still a positive result for growth; it just tells you the organism is a non-lactose fermenter.
You suspect a Gram-positive is actually growing
If you genuinely suspect a Gram-positive organism is present based on colony morphology or other evidence, do a Gram stain on a picked colony. That is the fastest confirmatory step. If the stain shows Gram-positive cocci or rods, you have either a contaminated plate, an enterococcal breakthrough, or a rare exception with your specific media lot. Follow up with a catalase test and appropriate selective media like mannitol salt agar (for staphylococci) or bile-esculin agar (for enterococci) to confirm the identity.
Confirmatory next steps in a workflow
- Gram stain any suspicious or unexpected colony directly from the MacConkey plate.
- If Gram-negative is confirmed, use additional differential tests: oxidase test (positive = likely Pseudomonas or other non-enteric Gram-negative; negative = likely Enterobacteriaceae), TSI or Kligler's agar for sugar fermentation patterns, indole test for E. coli confirmation.
- If Gram-positive is confirmed, transfer to appropriate selective media (mannitol salt agar for staphylococci, bile-esculin or blood agar for enterococci) and repeat identification.
- For food safety workflows following FDA BAM protocols, do not rely on MacConkey colony appearance alone. Colony color is presumptive; biochemical or molecular confirmation is required.
- If you are troubleshooting Burkholderia cepacia complex, note that MacConkey recovery is unreliable and dedicated selective media give far better results.
- Check your media lot and expiration date. Degraded crystal violet or bile salts can reduce selectivity, allowing Gram-positive breakthrough that would not occur on a fresh lot.
MacConkey agar is a powerful tool when used correctly and interpreted within its designed limits. Its selectivity against Gram-positives is one of its greatest strengths in food and environmental microbiology, but that strength depends on fresh media, correct incubation, and appropriate downstream confirmation. A plate reading is a starting point, not a final answer.
FAQ
Can I use MacConkey agar to detect Gram-positive bacteria if they are supposed to be inhibited?
Not reliably. Even when rare Gram-positive breakthrough occurs, it is usually sparse and weak, and color can be misleading. If your goal is to detect or quantify Gram-positives, use a Gram-positive selective medium (for example, mannitol salt agar for staphylococci or bile-esculin for enterococci) and confirm with targeted tests after pick and re-streak.
If a plate incubates longer than 24 hours, could it start showing Gram-positive growth that would not appear on a correct schedule?
Yes. Extended incubation beyond about 48 hours can cause misleading breakthrough, including colonies from weakly inhibited organisms and changes in indicator background. The practical fix is to read and document colony counts at the intended time window and repeat with fresh plates if the incubation was not controlled.
Why might I see pink or reddish colonies that look like lactose fermenters, even though Gram-positives usually do not grow on MacConkey?
Two common causes are (1) very heavy inoculum, which can increase survival of a few sensitive cells and produce atypical weak color, and (2) media lot or formulation differences, where some vendors’ crystal violet or bile salt levels allow more enterococcal breakthrough. Verification requires re-pick, Gram stain, and confirmatory biochemical or selective assays.
Is it safe to assume that all robust growth on MacConkey is Gram-negative?
Under standard selective conditions, it is a strong first assumption, but not an absolute rule. The main exceptions are occasional enterococcal recovery (typically faint or pale color) and rare formulation-dependent breakthrough. Confirm identity before reporting by doing a Gram stain on a colony and following with catalase and appropriate selective/differential tests.
How can I tell whether a Gram-positive signal is true growth versus contamination or survival?
True growth usually produces consistent colony morphology and more developed colonies across streaks from a picked colony. Survival or “carryover” tends to be sparse and less developed. In both cases, re-streak from a single colony to confirm purity, then do a Gram stain and catalase to distinguish enterococci from other cocci.
Does the type of MacConkey agar (different brands, bile salt levels, crystal violet levels) change how often Gram-positives show breakthrough?
Yes. Slight formulation differences can shift how much Gram-positive tolerance is allowed, especially for enterococci. If you are investigating unexpected colonies, record the exact product name, lot number, and any technical sheet notes, then compare with expected behavior using a confirmatory medium like bile-esculin or mannitol salt agar as appropriate.
Can Proteus or other non-lactose fermenters confuse the interpretation of Gram-positive versus Gram-negative growth on MacConkey?
They can confuse lactose differentiation, not the selective logic. Non-lactose fermenters remain colorless on MacConkey even when they are Gram-negative, so colorless colonies are still considered positive growth. Use Gram stain and, if relevant, confirmatory identification tests to avoid misattributing growth type based only on colony color.
What should I do if my MacConkey control performance is off, for example, if I get unusually much Gram-positive-like growth?
Check media storage and age (dried or expired plates can perform differently), verify incubation time and temperature, and confirm that the plate you used is the intended MacConkey formulation. Then test with known control strains from your lab to determine whether the issue is media quality, technique, or incubation conditions.
Can Bacteria Grow in Vinegar? pH, Survival, and Safety Tips
Explore if bacteria can grow in vinegar, how pH and dilution affect survival, and practical food-safety storage tips.


